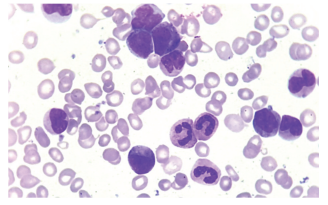
Enunciado 3685605-1

Foram encontradas 60 questões.
Uma pesquisadora está estudando a heterogeneidade celular
em um tumor de mama agressivo e deseja identificar
variações genômicas e transcriptômicas entre as células do
tumor. Ela pretende investigar quais mutações específicas
podem estar associadas à resistência a tratamentos e como
diferentes subpopulações celulares contribuem para a
progressão tumoral. Considerando a complexidade do tecido,
a pesquisadora decide utilizar uma abordagem de
sequenciamento de células únicas (single-cell sequencing).
Após a análise dos dados, ela observa que algumas células
apresentam mutações raras que não foram detectadas em
sequenciamentos convencionais de DNA tumoral a granel
(bulk sequencing). Além disso, a expressão gênica varia
significativamente entre diferentes populações celulares
dentro do mesmo tumor. Com base nesse caso, assinale a
alternativa que apresenta a principal vantagem do single-cell
sequencing em relação ao sequenciamento convencional.
Provas
Questão presente nas seguintes provas
Uma equipe de pesquisadores está investigando novas
abordagens terapêuticas para a Leucemia Mieloide Aguda
(LMA). Para entender melhor os mecanismos da doença e
testar novos tratamentos, eles utilizam um modelo de
camundongo geneticamente modificado, no qual foi inserida
uma mutação específica no gene FLT3, frequentemente
encontrada em pacientes com LMA. Após a introdução da
mutação, os camundongos desenvolvem características
clínicas semelhantes às observadas em humanos com a
doença, incluindo proliferação descontrolada de células
hematopoiéticas imaturas. Os pesquisadores então começam
a testar um novo inibidor de FLT3 nesses camundongos,
avaliando sua eficácia na redução da carga tumoral e na
melhora da sobrevida. Com base no caso apresentado,
assinale a alternativa que apresenta a principal vantagem no
uso de animais geneticamente modificados no estudo de
doenças hematopoiéticas.
Provas
Questão presente nas seguintes provas
A respeito da citometria de alta dimensão, é correto afirmar:
Provas
Questão presente nas seguintes provas
Um paciente de 65 anos apresentou fadiga, esplenomegalia e
infecções recorrentes. O hemograma revelou pancitopenia e
um aumento discreto de linfócitos circulantes. O médico
solicitou uma citometria de fluxo para caracterizar a população
celular, e os achados laboratoriais revelaram uma população
monoclonal de células B expressando CD19, CD20 forte,
CD22, CD11c, CD25 e CD103. Com base nesses achados,
assinale a alternativa que apresenta o diagnóstico mais
provável.
Provas
Questão presente nas seguintes provas
Paciente do sexo masculino, 42 anos, apresenta fadiga
progressiva e dor no abdômen superior nos últimos 3 meses.
Relata perda de peso não intencional e episódios de febre
baixa. O paciente tem antecedentes de hipertensão
controlada e não apresenta histórico familiar relevante de
câncer. Ao exame físico, apresenta esplenomegalia moderada
(baço palpável a 3 cm abaixo do rebordo costal) e
linfadenopatia discreta (gânglios palpáveis, mas não
dolorosos).
• Hemograma:
Leucócitos elevados (25.000/μL, com desvio à esquerda); Hemoglobina ligeiramente reduzida (11,5 g/dL); Plaquetas aumentadas (450.000/μL); Presença de mielócitos, metamielócitos e bastões.
O resultado do esfregaço de sangue periférico pode ser observado na imagem a seguir:

Com base na imagem do esfregaço de sangue periférico e nos achados clínicos e laboratoriais, assinale a alternativa que apresenta o diagnóstico mais provável.
• Hemograma:
Leucócitos elevados (25.000/μL, com desvio à esquerda); Hemoglobina ligeiramente reduzida (11,5 g/dL); Plaquetas aumentadas (450.000/μL); Presença de mielócitos, metamielócitos e bastões.
O resultado do esfregaço de sangue periférico pode ser observado na imagem a seguir:
Com base na imagem do esfregaço de sangue periférico e nos achados clínicos e laboratoriais, assinale a alternativa que apresenta o diagnóstico mais provável.
Provas
Questão presente nas seguintes provas
Um hematologista está investigando um paciente de 45 anos
que apresenta fadiga intensa, linfadenopatia generalizada e
esplenomegalia. O hemograma revelou linfocitose persistente
e a análise morfológica mostrou linfócitos pequenos com
núcleo irregular no esfregaço sanguíneo periférico. Para
esclarecer o diagnóstico, o médico solicita uma citometria de
fluxo com painel imunofenotípico de linfócitos B. Os resultados
indicam a presença de células CD19⁺, CD5⁺, CD23⁺, CD20 de
baixa intensidade e expressão de cadeias leves restritas de
imunoglobulina. Com base nesses achados, assinale a
alternativa que apresenta o diagnóstico mais provável.
Provas
Questão presente nas seguintes provas
No citômetro de fluxo, a luz interage com as células em
suspensão quando elas passam individualmente por um feixe
de luz. Esse processo gera dois tipos principais de dispersão
da luz, que são medidos por detectores no equipamento,
conforme demonstrado na imagem a seguir:

Com base nas informações apresentadas, assinale a alternativa correta.

Com base nas informações apresentadas, assinale a alternativa correta.
Provas
Questão presente nas seguintes provas
O mieloma múltiplo é uma neoplasia hematológica de células
plasmáticas malignas, caracterizada pela proliferação
descontrolada de plasmócitos clonais na medula óssea. Esses
plasmócitos anormais produzem grandes quantidades de
proteínas monoclonais (imunoglobulinas), levando a
complicações como lesões ósseas líticas, hipercalcemia,
insuficiência renal e anemia. Uma das características
morfológicas observadas em mieloma múltiplo é a presença
de células de Mott no esfregaço sanguíneo periférico. Assinale
a alternativa que apresenta um linfócito com morfologia
característica da célula de Mott.
Provas
Questão presente nas seguintes provas
Assinale a alternativa que descreve corretamente a diferença
entre imunodeficiência primária e secundária.
Provas
Questão presente nas seguintes provas
Um laboratório de hematologia está investigando a
proliferação de células-tronco hematopoiéticas em um
paciente com Leucemia Mieloide Aguda (LMA). O estudo
possuí como objetivo avaliar a capacidade das células-tronco
de se diferenciarem em diferentes linhagens celulares
hematopoéticas e responder a estímulos específicos. Para
isso, a equipe decide utilizar uma técnica de cultura celular
que possibilite a proliferação e diferenciação das células
hematopoiéticas, sem que estas percam a capacidade de se
autorrenovar. Com base na situação apresentada, assinale a
alternativa que descreve corretamente a técnica de cultura
celular mais indicada para o objetivo do estudo.
Provas
Questão presente nas seguintes provas
Cadernos
Caderno Container